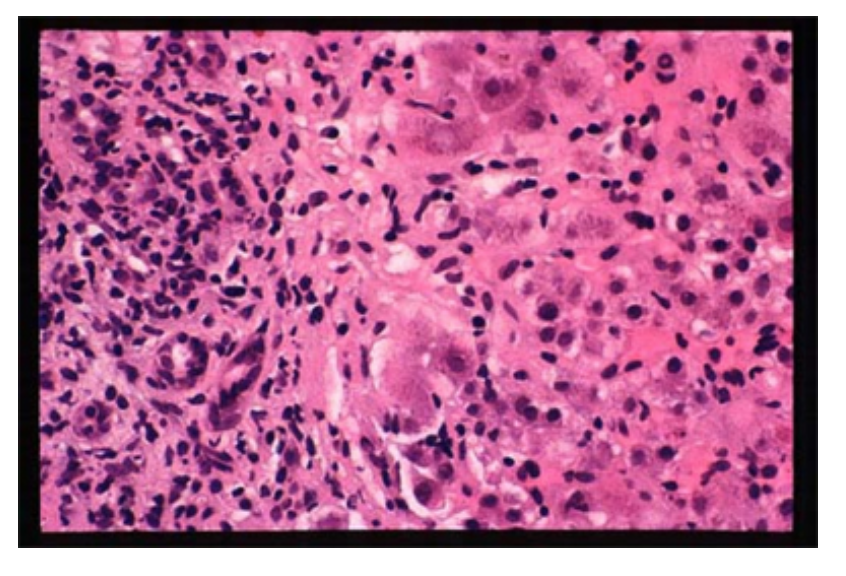

70y M
surgical outpatient clinic
change in bowel habit 3months - increased freq of loose stools and occasional constipation
systemically unwell - malaise, lethargy, reduced appetite, nausea but no vomiting, night sweats, difficulty sleeping
lost 3kg weight past month
no blood in stool
civil engineer - work in developing countries
apyrexial
abdo - fullness in right iliac fossa - tender
no lymphadenopathy
Hb 99 (135-180 g/L)
WCC 8 (4-11 x109/L)
MCV 85 (76-100 fL)
Na+ 141 (136-145 mM)
K+ 4.2 (3.5-5.1 mM)
Ur 7.3 (1.7-8.3 mM)
Cr 80 (62-106 µM)
Alb 30 (35-52 g/L)
CRP 43 (0-5 mg/L)
ESR 56 (0-15 mm/h)
which two investigations will be most helpful
how urgently should these investigations be requested
CT abdo pelvis
colonoscopy - allows for histological diagnosis
done within 2 weeks - high suspicion of malignancy
what are associated with right iliac fossa mass
caecal carcinoma
appendix abscess
chrons disease
hepatomegaly - can extend into RIF and so can the normal variant, Riedel’s lobe
CT scan - inflammatory stricturing of the caecum and terminal ileum.
colonoscopy - significant inflammatory change in the caecum and terminal ileum.
Biopsies were taken from this area.
The colonoscopic and radiographic appearances suggest Crohn’s disease or infection.
What two infectious organisms could be responsible?
Tuberculosis
Yersinia
patient has ileal-caecal TB
tuberculosis and yersinia can both mimic ileo-caecal chrons disease
CXR should be performed to demonstrate previous/active pulmonary TB (half of patients dont present with hx of pulmonary TB)
rare causes in UK - look for travel in hx
colonoscopic and radiographic appearances suggest Chron’s disease or infection
Histology confirmed diffuse infiltration of the caecum and terminal ileum, with the presence of non-caseating granulomas as well as mixed acute and chronic inflammatory changes.
no evidence of carcinoma or lymphoma
productive cough for few weeks - one episode of haemoptysis
CXR - what are the findings?
most likely underlying diagnosis given the chest radiograph?
would you be confident to diagnose chrons and start on steroids?

bilateral ill defined upper lobe infiltrates/consolidation
tuberculosis
no - TB more likely with CXR findings - treat TB after obtaining sputum sample
management for TB
RIPE
Rifampicin - 6 months
Isoniazide - 6 months
Pyrazinamide - 2 months
Ethambutol - 2 months
24yr W
presents to GP with husband
eyes looked yellow for past 3 days
2 wk hx lethargy, anorexia, non-specific upper abdo pain
no alcohol excess
no travel abroad recently
4months ago - borderline hypothyroidism - no treatment
jaundiced but euthyroid (normal thyroid function)
multiple spider naevi on anterior chest wall
liver palpable 3cm below costal margin
spleen palpable 2cm below costal margin
Hb 119 120-155 g/L
WCC 4.5 4-11 x109/L
Plt 156 150-450 x109/L
Ferritin 670 13-150 µg/L high
Bili 56 2-17 µM high
ALP 230 35-104 iu/L high
ALT1230 <31 IU/L high
INR 1.0 0.9-1.2
what are the three main differential diagnoses at this stage
autoimmune hepatitis (particularly in young women) - can develop spider naevi and enlarged spleen even without cirrhosis
viral hepatitis
- hepatits likely diagnosis as spider naevi and splenomegaly suggest cirrhosis/ portal HTN (doesnt fit thyroid disease)
non-alcoholic fatty liver disease (but doesnt usually present acutely with jaundice)
hypo and hyperthyroidism –> abnormal LFTs and jaundice (in severe disease and with coexisting heart failure)
high ferritin reflects acute phase response - hemochromatosis (excess iron –> liver damage) presents after 5th decade <– normal transaminases in haemochromatosis
24yr W
presents to GP with husband
eyes looked yellow for past 3 days
2 wk hx lethargy, anorexia, non-specific upper abdo pain
no alcohol excess
no travel abroad recently
4months ago - borderline hypothyroidism - no treatment
jaundiced but euthyroid (normal thyroid function)
multiple spider naevi on anterior chest wall
liver palpable 3cm below costal margin
spleen palpable 2cm below costal margin
ALT significantly raised
ALP and bilirubin raised
ferritin significantly raised
viral serology -ve
total protein and serum globulins raised
ANA +ve
smooth muscle antibody (SMA) +ve
liver ultrasound normal
most appropriate next step in management
liver biopsy
- high clinical suspicion of AIH (type 1) - cant be diagnosed without liver histology
after diagnosis:
high dose steroids then addition of azathioprine
test TMPT levels (chemical in bone) before starting azathiaprine - can cause myelosuppression
24yr W
presents to GP with husband
eyes looked yellow for past 3 days
2 wk hx lethargy, anorexia, non-specific upper abdo pain
no alcohol excess
no travel abroad recently
4months ago - borderline hypothyroidism - no treatment
jaundiced but euthyroid (normal thyroid function)
multiple spider naevi on anterior chest wall
liver palpable 3cm below costal margin
spleen palpable 2cm below costal margin
ALT significantly raised
ALP and bilirubin raised
ferritin significantly raised
viral serology -ve
total protein and serum globulins raised
ANA +ve
smooth muscle antibody (SMA) +ve
liver ultrasound normal
percutaneous liver biopsy (shown in pic)
what is the most likely diagnosis
autoimmune hepatitis
florid interface hepatitis (ie inflammation spilling over the portal tract limiting membrane on to the hepatocytes)
inflammatory exudate is rich in plasma cells
AIH most likely - female, elevated globulins, -ve viral serologies, no drug hx
bile ducts normal therefore primary biliary cholangitis unlikely
24yr W
presents to GP with husband
eyes looked yellow for past 3 days
2 wk hx lethargy, anorexia, non-specific upper abdo pain
no alcohol excess
no travel abroad recently
4months ago - borderline hypothyroidism - no treatment
jaundiced but euthyroid (normal thyroid function)
multiple spider naevi on anterior chest wall
liver palpable 3cm below costal margin
spleen palpable 2cm below costal margin
ALT significantly raised
ALP and bilirubin raised
ferritin significantly raised
viral serology -ve
total protein and serum globulins raised
ANA +ve
smooth muscle antibody (SMA) +ve
liver ultrasound normal
percutaneous liver biopsy (shown in pic)
started on Prednisolone 30mg - rapid clinical and biochem remission
azathiprine added and steroids tapered
after 3months LFT normal, asymptomatic
daily meds: pred 5mg, azathioprine 50mg
she requests if she can discontinue her drugs - what should you advise?

AIH therapy at least two yrs after blood tests have normalised before discontinuing therapy
liver biopsy before stopping therapy
if stopped before two yrs most patients relapse
life long therapy: patients with cirrhosis, severe initial presentation, prior relapse
patient is on azathioprine for autoimmune hepatitis. patient informs you that they are 12 weeks pregnant. she has read up about the side effects of azathioprine and is concerned. what should be your advice
continue current medication
safe to be on azathioprine whilst pregnant
risk of stopping is greater than risk of teratogenic effects
what are the signs and symptoms of autoimmune hepatitis
female
jaundice
hepatosplenomegaly
raised LFTS
-ve viral serology
+ve ANA and SMA
79yr M
acute stroke
unsafe swallow
NG tube inserted but hard to aspirate any gastric contents
most appropriate next management step
CXR
must be confirmed in right position before being flushed or used
CXR shown below
what position is the NG tube

down the right main bronchus
what should the pH level be between for an NG tube aspirate to check if its in the right position
what if the pH is not within range
pH btwn 1-5.5
if not within range or aspirate cant be obtained - CXR
58yr M
gastro outpatients
4month hx gradually progressive dysphagia
initially discomfort with solids now cant tolerate solids and only small quantities of fluid
hx of probable GORD with heartburn and belching over yrs
weight loss 6mnths
10-15 cigarettes per day
drinks 2-3 pints per day
meds: antacid liquid med
no lymphadenopathy
no abdo masses
two most likely diagnoses
most appropriate next investigation
oesophageal stricture:
peptic stricture (hx of GORD more likely to mean peptic in origin)
oesophageal carcinoma
oesophagogastroduodenoscopy (OGD) - 2ww pathway
- would diagnose peptic stricture and oesophageal carcinoma
OGD shows stricture in lower third of oesophagus
biopsies show inflammation only
which two initial treatments should this patient be offered
proton pump inhibitor
balloon dilatation, following benign biopsy - treatment for symptomatic benign peptic strictures
endoscopy and biopsy confirmation of benign disease needed
treatment of GORD - PPI
patient underwent balloon dilation of peptic stricture
immediately post-procedure he experienced chest pain and SOB
which diagnosis would you consider
which further investigations would you arrange urgently
oesophageal perforation
- most common complication of balloon dilatation - may cause mediastinitis. surgical emphysema may be palpable in neck
do CT scan with oral contrast - for perforation post-oesophageal dilatation suspected
presentation of peptic ulcer disease
epigastric pain
dyspepsia (indigestion)
heartburn
duodenal - pain may be relived by eating
gastric - pain with meals
causes of peptic ulcer
h.pylori
NSAIDs
also consider steroids, alcohol, SSRIs
complications of peptic ulcers
haematemesis (erosion usually into gastroduodenal artery)
perforation (peritonitic)
can also see malaena, anaemia, weight loss
investigations for peptic ulcer disease
first Ix: H.pylori breath test
ALARM syptoms: endoscopy
- Anorexia
- Loss of weight
- Anaemia due to iron deficiency
- Recent onset of persistent symptoms: vomiting
- Malaena, haematemesis
>55 + weight loss + upper abdo pain/reflux/ dyspepsia –> endoscopy
new onset dysphagia –> endoscopy
management for peptic ulcer disease
if h.pylori +ve –> triple therapy:
- one week triple therapy: PPI + clarithromycin + amoxicillin/metronidazole
review after 4 weeks with urea breath test - if not eradicated repeat Rx
if h.pylori -ve: PPI or H2 antagonist (ranitidine) for 4weeks





























